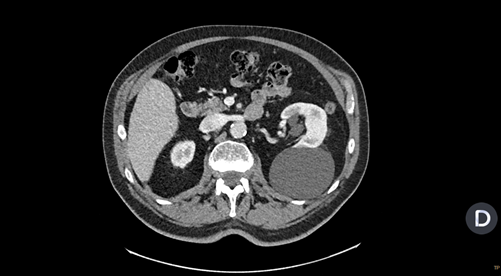

X Jornadas de Actualización en Medicina de Urgencias y VI Jornadas de Ecografía de la semFYC
6-7-8 de febrero de 2025
Atención Primaria.
Hombre de 83 años que consulta por dolor costal izquierdo de meses de evolución, recurrente, no mecánico y que el paciente define como un dolor «interno». Refiere que hace muchos años le hicieron una ecografía y le dijeron que tenía un gran quiste renal Izquierdo, pero que le dijeron que no había que hacer nada.
Se revisa la historia clínica y consta ecografía renovesical donde informan de quiste simple renal izquierdo de 4 cm de diámetro.
Se le explica que es correcto, que los quistes simples renales son asintomáticos, benignos y que no requieren ni seguimiento ni tratamiento.
Antecedentes personales relevantes, anamnesis, exploración física y lugar que ocupa en ella la ecografía
Bronquiectasias en seguimiento con neumología.
HBP en tratamiento médico.
Exploración física anodina.
Estudio radiológico columna dorsal y lumbar con signos degenerativos.
En este momento no se plantea completar el estudio con una ecografía.
Descripción de los hallazgos ecográficos y las imágenes más relevantes para la resolución del caso
Consulta a urgencies por otro motivo no relacionado con el motivo de consulta por el cual se le realiza un TC torácico y revisando las imágenes se observa una imagen redondeada de márgenes bien delimitados dependiente de riñón izquierdo y que contacta con musculatura paravertebral y costal izquierda.
Se realiza ecografía renal a primaria que objectiva una imagen anecoica a nivel de polo superior de riñón izquierdo de 13 x 9 cm que no capta Doppler compatible com un quiste simple renal (Bosniak I).
Otras pruebas complementarias realizadas (si existen)
No se realizan más exploraciones.
Juicio clínico, diagnóstico diferencial, concordancia con el hospital (en su caso)
Ante estos hallazgos se plantea la duda de si el dolor costal que refiere realmente podría ser secundario a la compresión a nivel de musculatura paravertebral y costal izquierdas y se revisa la literatura donde se describe el dolor en flanco como una posible manifestación clínica de los quistes renales, aunque no la más frecuente.
Decisiones adoptadas: tratamiento, planes de actuación
Se decide derivar a urología para valoración.
Evolución y seguimiento
Pendiente de valoración por parte de urología.